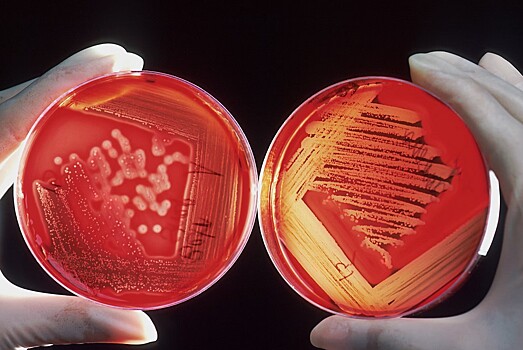
Десерт для бактерий: кто придумал использовать агар в микробиологии

Десерт для бактерий: кто придумал использовать агар в микробиологии
Для изучения микроорганизмов в лабораториях ученые используют довольно необычный инструмент — агар. Желатиновую субстанцию, которая неожиданно хорошо поддерживает развитие бактерий. Журнал Smithsonian рассказал, кто стоял за этим открытием.
Агар не всегда выполнял функцию медиума в лабораторных исследованиях. До XIX века его чаще всего использовали как ингредиент в десертах и супах. Для контекста, ученые того времени не имели способа выращивания микроорганизмов в качестве чистых культур, изолированных от других видов. А это ключевой шаг в поиске лекарств от болезней, вызванных микроорганизмами.
Твердые субстанции, типа картофельных долек или застывшие яичные белки, создавали сложности. Если точнее, проблемой была их непрозрачность. Желатин на их фоне выглядел чуть более практичным, но бактерии легко пожирали вещество, не говоря уже о том, что оно таяло при высоких температурах, необходимых для культивации микробов. Добавление агара в питательную смесь позволяло создать прозрачный медиум, который не пострадал бы от активности бактерий.
За революцию в микробиологии ответственна Фанни Гессе — американо-немецкая ученая, которая однажды предложила своему мужу, биологу Вальтеру Гессе, желатин на агар. Она часто использовала агар на кухне для приготовления фруктовых и овощных желе. Многие пудинги в Индонезии как раз содержат этот ингредиент, и Фанни узнала о кулинарных свойствах агара от соседки, некогда жившей в датской колонии.
Несмотря на важность агара для науки, мало кто помнит роль, которую Гессе сыграла в истории микробиологии. Фанни часто представляли преимущественно домохозяйкой, однако новые документы, которыми поделились ее потомки, открыли истинные таланты ученой. Помимо всего прочего, она была успешным научным иллюстратором. Фанни помогала своему мужу во многих проектах, создавая рисунки микроскопических образцов для научных публикаций.
Популярные работы по истории микробиологии иногда присваивают первое использование агара в лабораторных условиях знаменитому исследователю Роберту Коху. Даже он сам в своих лекциях упоминал важность агара, но не говорил о том, что открытие принадлежит Гессе. Да и сами супруги не публиковали научные работы о новом медиуме — возможно, из-за этого их вклад в микробиологию и не получил широко признания.
Тем не менее, идеи Гессе не пропали даром. Агар по-прежнему играет важнейшую роль в науке. Он послужил плацдармом для бесчисленного множества крупных открытий, от антибиотиков до инструментов генного редактирования, вроде CRISPR. Именно поэтому недавний дефицит водорослей, возникший из-за чрезмерного промысла, вызвал панику в научных кругах.